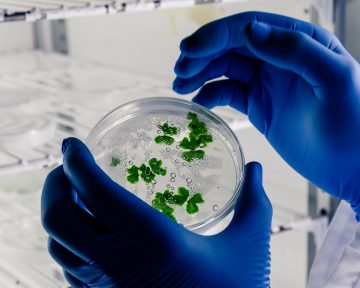

Виробництво рекомбінантних ліків з використанням методів біотехнології рослин відоме як молекулярний фармінг. Роблячи високоефективні та економічно ефективні ліки доступними для широких верств населення, ця методика має потенціал для революції у фармацевтичній промисловості. Експресія білків у рослинах безпечніша, продуктивніша та економічно доцільніша. Крім того, попит на молекулярну фармацію зростає, що сприятиме зростанню цього ринку в наступні 5 років.
Виробництво рекомбінантних ліків з використанням методів біотехнології рослин відоме як молекулярний фармінг. Роблячи високоефективні та економічно ефективні ліки доступними для широких верств населення, ця методика має потенціал для революції у фармацевтичній промисловості. Експресія білків у рослинах безпечніша, продуктивніша та економічно доцільніша. Крім того, попит на молекулярну фармацію зростає, що сприятиме зростанню цього ринку в наступні 5 років.Читати далі: https://ift.tt/pcQ74if
apteka.ua
Приєднуйся у Telegram канал: https://t.me/apteca
або Viber канал: http://bit.ly/3XCHfEc

Немає коментарів:
Дописати коментар